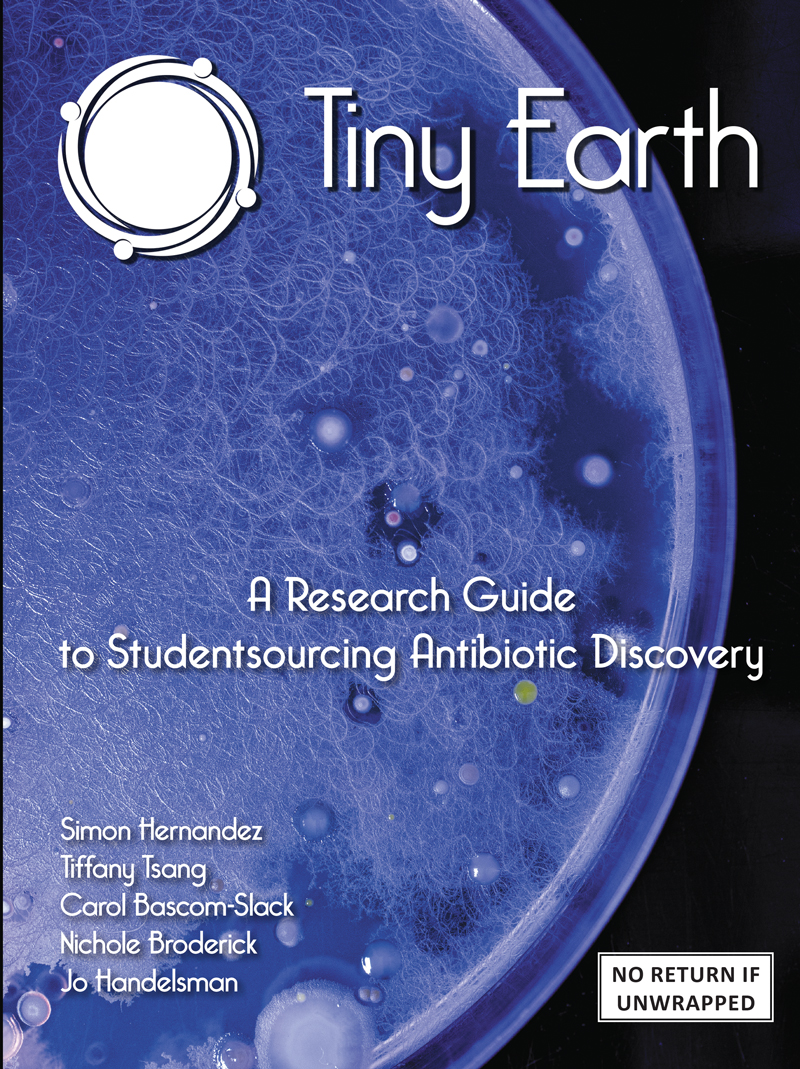

Studentsourcing Antibiotic Discovery
Addressing a looming health crisis by engaging students in research and discovery
About Tiny Earth
Our Mission
Tiny Earth inspires and retains students in the sciences while addressing one of the most pressing global health challenges of our century: the diminishing supply of effective antibiotics. Tiny Earth is an undergraduate research course where students discover antibiotics from soil bacteria in their own backyards.
This innovative, international network of students and Tiny Earth Partner Instructors (TEPIs) was created by Dr. Jo Handelsman, Vilas Research Professor of Plant Pathology at the University of Wisconsin–Madison and former Associate Director for Science at the White House Office of Science and Technology Policy (OSTP).
A Message From the Founder
“Students have the capacity to solve the antibiotic resistance crisis by discovering many new antibiotics through their sheer numbers as well as the ingenuity that they bring to the research.”
—Dr. Jo Handelsman, Founder, Tiny Earth
What is Tiny Earth?
Video created by students Pari Patel and Nikhila K. Reddy at California Northstate University: College of Health Sciences with the guidance of TEPI Dr. Parisa Jazbi.
Tiny Earth Student Guide
The Tiny Earth Student Research Guide contains content and lab protocols that guide students in discovering antibiotic-producing bacteria from soil.
Connect With Tiny Earth
Tiny Earth Partner Instructors (TEPIs) teach Tiny Earth students all over the globe to develop and test hypotheses, collect soil, isolate bacteria, screen for antibiotic activity, and log data in the Tiny Earth Discovery Database.
Connect with other TEPIs and Tiny Earth students through social media and events!
A Network of Instructors and Students
Tiny Earth Partner Instructors
Tiny Earth Partner Instructors (TEPIs) are trained in Tiny Earth pedagogy, Scientific Teaching methods, and are connected to the network of over 900 other TEPIs worldwide. Learn more and apply to become a TEPI today!
Studentsourcing Antibiotic Discovery
Over 18,000 students (Tiny Earthlings) take Tiny Earth research courses every year, learning about soils, isolating antibiotic-producing bacteria from soil, and characterizing isolates with molecular, chemical, and microscopy techniques. Students enter data into the Tiny Earth Database for use across the network.
Upcoming Events
Featured Publications
Tiny Earth is committed to scholarship in research, teaching, and learning. Here are a few of our publications from the leadership team to illustrate the scientific and educational expertise in Tiny Earth.
Tiny Earth CURE Demonstrates Equitable Benefits for U.S. College Science Students
Miller, et al. CBE-Life Sciences Education (2025)
Gil-Serna, et al. Microbial Biotechnology (2025)
Tiny Earth: A Big Idea for STEM Education and Antibiotic Discovery
Hurley, et al. mBio (2021)
Tiny Earth addresses science education, health, and climate crises through 3 core goals.

Tiny Earth News
Book Cover Photo Contest
The cover of the current edition of the Tiny Earth Student Research Guide was taken by Tiny Earth Partner Instructor (TEPI) Victor Cid (Complutense University [...]
Research is for Everyone — A Tiny Earth Student’s Story on Being a Woman in STEM
When Tiny Earth undergraduate student Tasha Miller returned to school after working in pharmacies for years, she pictured herself attending pharmacy school, a goal that promised the [...]
Tiny Earth in Titletown Winter Symposium Recap
Over 500 students and community members gathered at Lambeau Field in Green Bay, Wisconsin for the 2025 Tiny Earth in Titletown Winter Symposium to share and gain knowledge about [...]
Support Tiny Earth
Give to Tiny Earth
The power of Tiny Earth is the rich network of students, instructors, and communities all working toward a common goal: antibiotic discovery. Gifts help to advance the discovery of new antibiotics and foster a talented STEM workforce of students by supporting educational programming, training new instructors, and hosting student research symposia.
Corporate Sponsors, Funding Agencies, and Institutional Support
Interested in sponsoring Tiny Earth?
For more information, check out our partnership page or email tinyearth@wid.wisc.edu.
Thank you for your support!
Order Tiny Earth Merchandise

Represent Tiny Earth in and out of the classroom! Show your love for Tiny Earth with premium short- and long-sleeve tees in your favorite color or a two-toned mug for your morning brew.
Purchases from the Tiny Earth merchandise store directly support Tiny Earth programming such as student research symposia and instructor training, keeping costs low for participants. Help us advance the discovery of new antibiotics and support STEM research and education by snagging Tiny Earth merchandise!